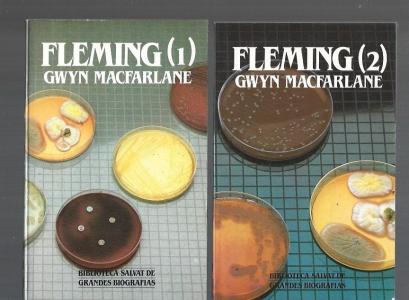

FLEMING (2 TOMOS)
DV0751843
FLEMING (2 TOMOS)
84-345-8145-0
SALVAT: BIBLIOTECA DE GRANDES BIOGRAFIAS
CASTELLANO
1985
Historia de la ciencia. Ciencia en general
TAPA BLANDA
1 KG
2 TOMOS-BUEN ESTADO
DESVÁN DEL LIBRO. C/Fernán González, 20. 28009 Madrid. España. Telf: +34 915776854